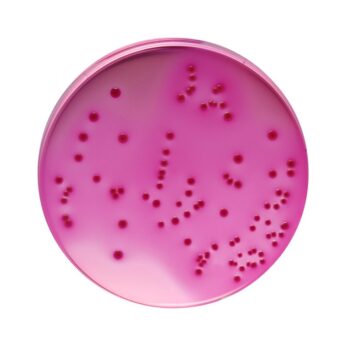
HiMedia GM049 - distributed by Immunomart

-
VF Selective Supplement 133 CADFor Research Use Only. Not for human or animal consumption, therapeutic, or diagnostic use.
Hi-Media catalog product. VF Selective Supplement.
For Research Use Only (RUO). Not for human or veterinary consumption, therapeutic, or diagnostic use.
-
VF Selective Supplement 346 CAD – 1,346 CADPrice range: 346 CAD through 1,346 CADFor Research Use Only. Not for human or animal consumption, therapeutic, or diagnostic use.
Hi-Media catalog product. VF Selective Supplement. Available in 2 sizes.
For Research Use Only (RUO). Not for human or veterinary consumption, therapeutic, or diagnostic use.
-
VIA Supplement 246 CADFor Research Use Only. Not for human or animal consumption, therapeutic, or diagnostic use.
Hi-Media catalog product. VIA Supplement.
For Research Use Only (RUO). Not for human or veterinary consumption, therapeutic, or diagnostic use.
-
Vibrio Agar 74 CAD – 2,254 CADPrice range: 74 CAD through 2,254 CADFor Research Use Only. Not for human or animal consumption, therapeutic, or diagnostic use.
Hi-Media catalog product. Vibrio Agar. Available in 4 sizes.
For Research Use Only (RUO). Not for human or veterinary consumption, therapeutic, or diagnostic use.
-
Vibrio HiVeg Agar 258 CAD – 2,254 CADPrice range: 258 CAD through 2,254 CADFor Research Use Only. Not for human or animal consumption, therapeutic, or diagnostic use.
Hi-Media catalog product. Vibrio HiVeg Agar. Available in 3 sizes.
For Research Use Only (RUO). Not for human or veterinary consumption, therapeutic, or diagnostic use.
-
Vibrio Parahaemolyticus Sucrose Agar 293 CAD – 2,558 CADPrice range: 293 CAD through 2,558 CADFor Research Use Only. Not for human or animal consumption, therapeutic, or diagnostic use.
Hi-Media catalog product. Vibrio Parahaemolyticus Sucrose Agar. Available in 3 sizes.
For Research Use Only (RUO). Not for human or veterinary consumption, therapeutic, or diagnostic use.
-
Vibrio Parahaemolyticus Sucrose HiVeg 293 CAD – 2,558 CADPrice range: 293 CAD through 2,558 CADFor Research Use Only. Not for human or animal consumption, therapeutic, or diagnostic use.
Hi-Media catalog product. Vibrio Parahaemolyticus Sucrose HiVeg. Available in 3 sizes.
For Research Use Only (RUO). Not for human or veterinary consumption, therapeutic, or diagnostic use.
-
Vibrio Vulnificus Agar (VVA) 371 CADFor Research Use Only. Not for human or animal consumption, therapeutic, or diagnostic use.
Hi-Media catalog product. Vibrio Vulnificus Agar (VVA).
For Research Use Only (RUO). Not for human or veterinary consumption, therapeutic, or diagnostic use.
-
Violet Red Bile Agar 253 CAD – 2,226 CADPrice range: 253 CAD through 2,226 CADFor Research Use Only. Not for human or animal consumption, therapeutic, or diagnostic use.
Hi-Media catalog product. Violet Red Bile Agar. Available in 3 sizes.
For Research Use Only (RUO). Not for human or veterinary consumption, therapeutic, or diagnostic use.
-
Violet Red Bile Agar 67 CAD – 7,210 CADPrice range: 67 CAD through 7,210 CADFor Research Use Only. Not for human or animal consumption, therapeutic, or diagnostic use.
Hi-Media catalog product. Violet Red Bile Agar. Available in 6 sizes.
For Research Use Only (RUO). Not for human or veterinary consumption, therapeutic, or diagnostic use.
Proudly representing





150+ years of combined research-supply heritage